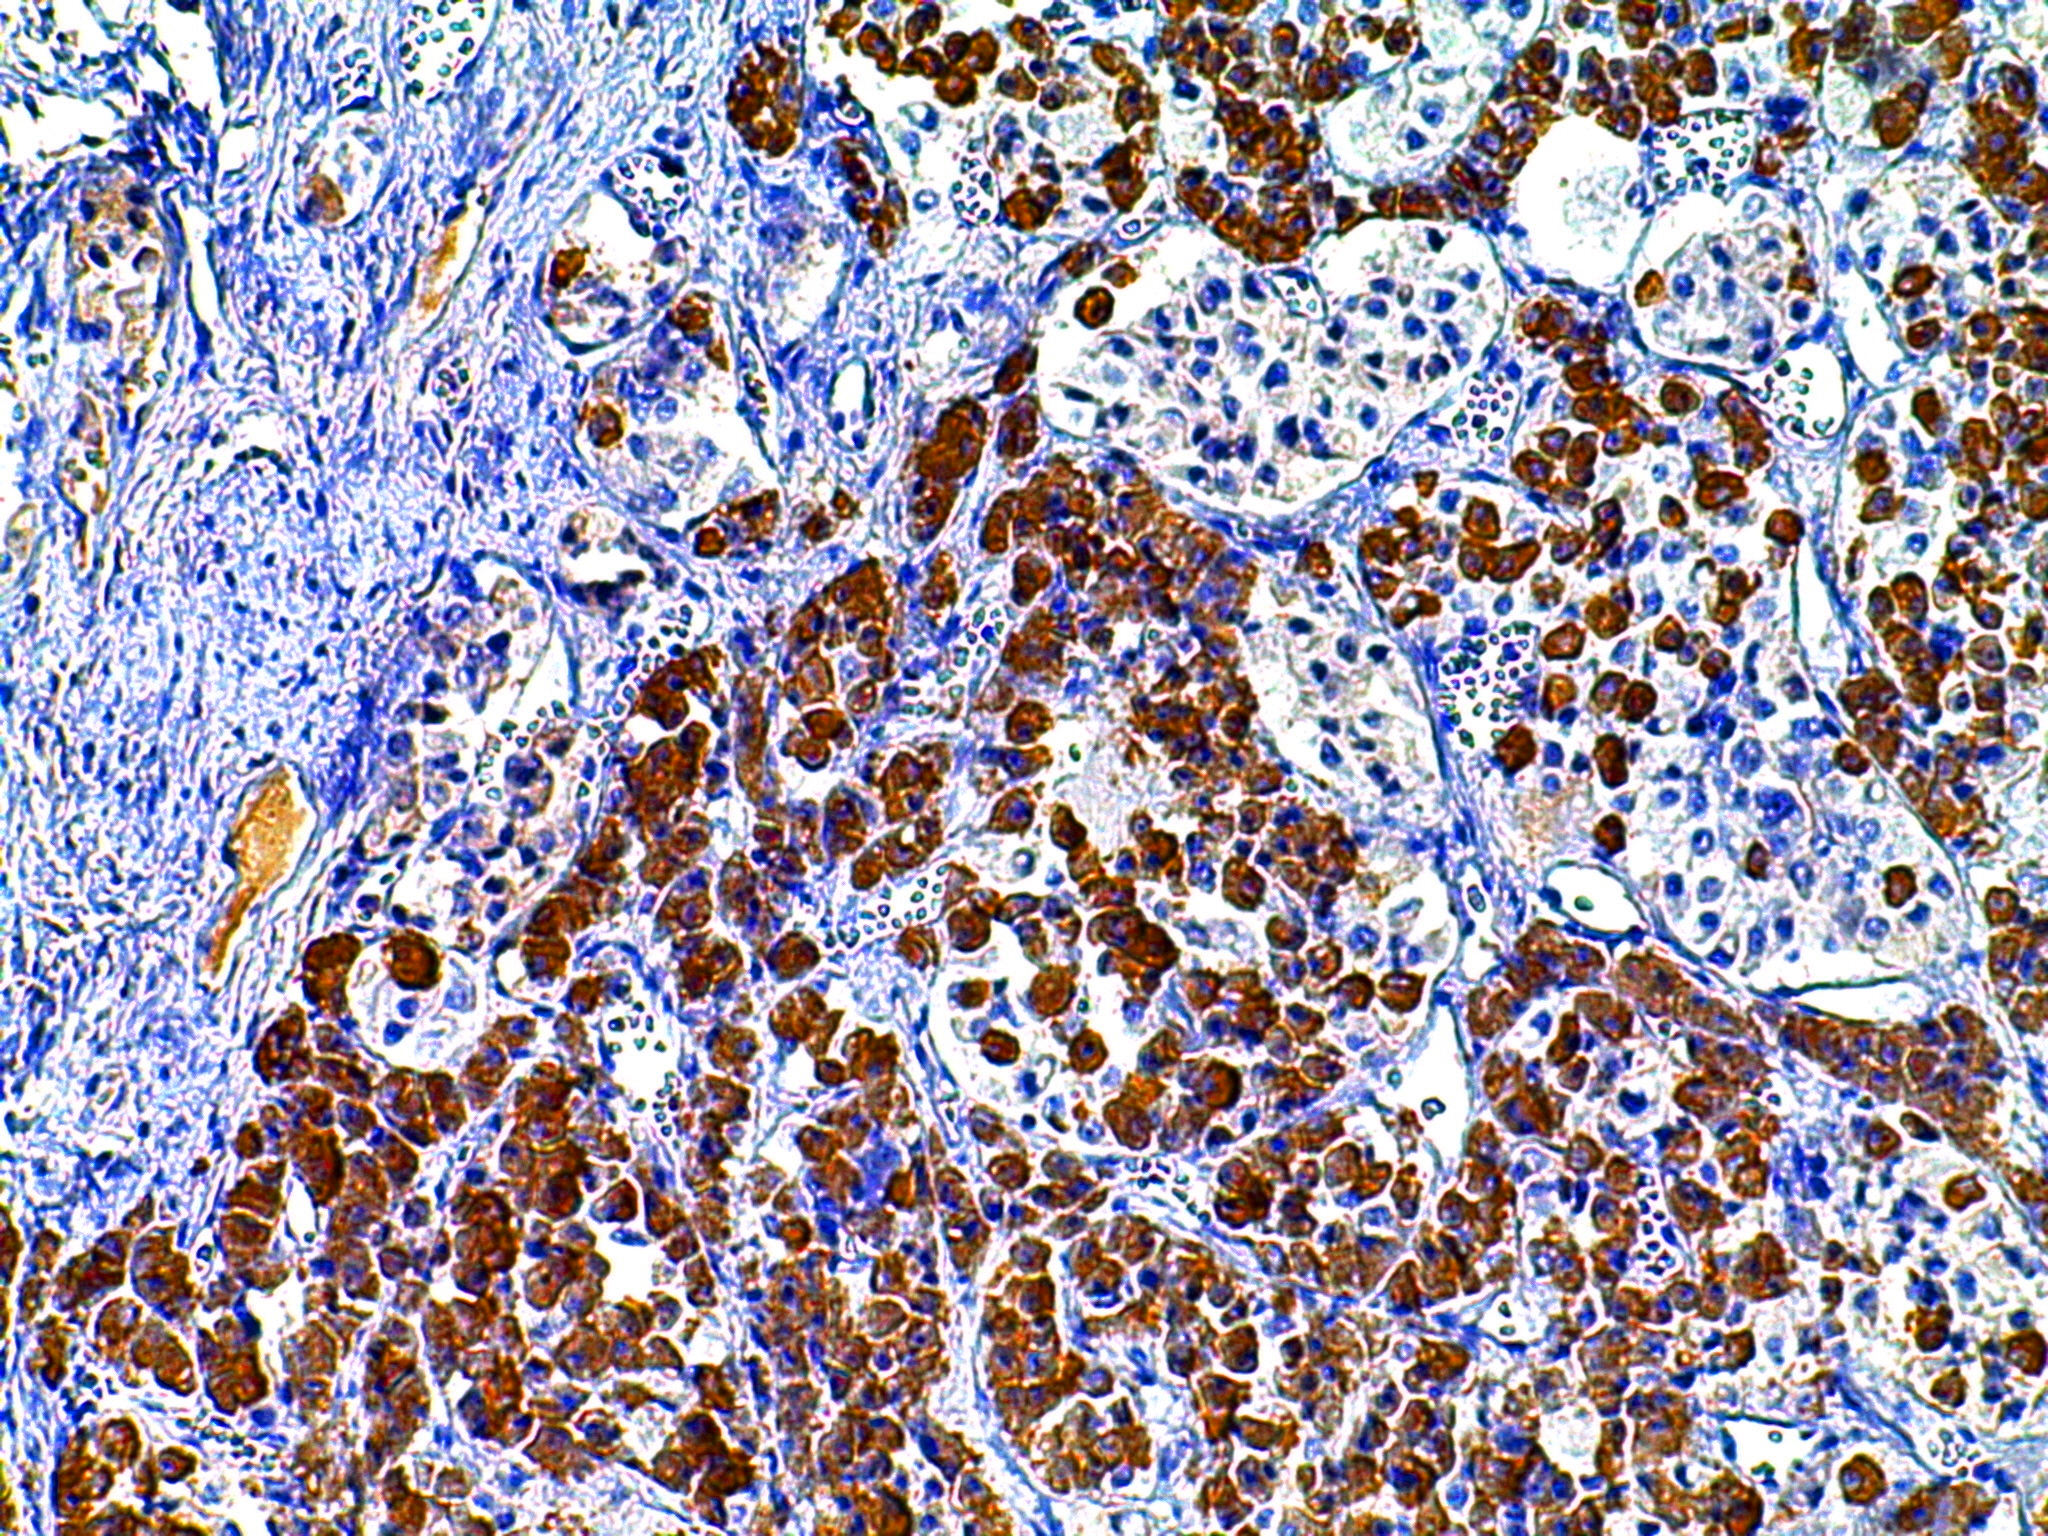
gh 垂体 胞浆

小鼠垂体切片

四,垂体
图片尺寸565x312
组织学与胚胎学 #组胚实验 #切片
图片尺寸1080x1439
垂体(嫌色细胞,嗜酸
图片尺寸1056x820
想请教小鼠下丘脑和垂体的解剖和取法,借助网上照片,想知道圈圈到底是
图片尺寸2048x1536
小鼠下丘脑和垂体的取出方法.
图片尺寸640x470
各位大佬好我已经将小鼠大脑取出如下图但还是无法定位垂体在哪想问问
图片尺寸1133x2453
显微镜下垂体横切面
图片尺寸1200x800
垂体(嫌色细胞,嗜酸/碱性细胞|神经部,远侧部,中间部)6.
图片尺寸966x693
垂体(嫌色细胞,嗜酸/碱性细胞|神经部,远侧部
图片尺寸1056x820
ttt/gf 小鼠垂体促甲状腺滤泡星状细胞
图片尺寸1351x1017
脾白髓甲状腺滤泡肾上腺皮质腺垂体远侧部肺呼吸部小肠绒毛胃底腺
图片尺寸1536x2048
各位大佬好我已经将小鼠大脑取出如下图但还是无法定位垂体在哪想问问
图片尺寸899x1947
组织学与胚胎学本科实验课件内分泌系统
图片尺寸800x600
及标注: 依次为:足底皮,人皮肤(表皮),人头皮,甲状腺,肾上腺,脑垂体
图片尺寸1446x761
gh 垂体 胞浆
图片尺寸2048x1536
att-20细胞-细胞系-小鼠垂体瘤细胞-上海中乔新舟生物科技有限公司
图片尺寸2592x1944
赫令体 垂体细胞 脑垂体的神经部
图片尺寸1080x810
组胚红蓝铅笔绘图 - 知乎
图片尺寸1492x1601
jvi|zikv感染导致下丘脑-垂体-性腺轴激素缺乏和生育能力下降
图片尺寸960x1121
4发表期刊:genome medicine文章题目:单细胞转录组学揭示了不同垂体
图片尺寸1080x1674